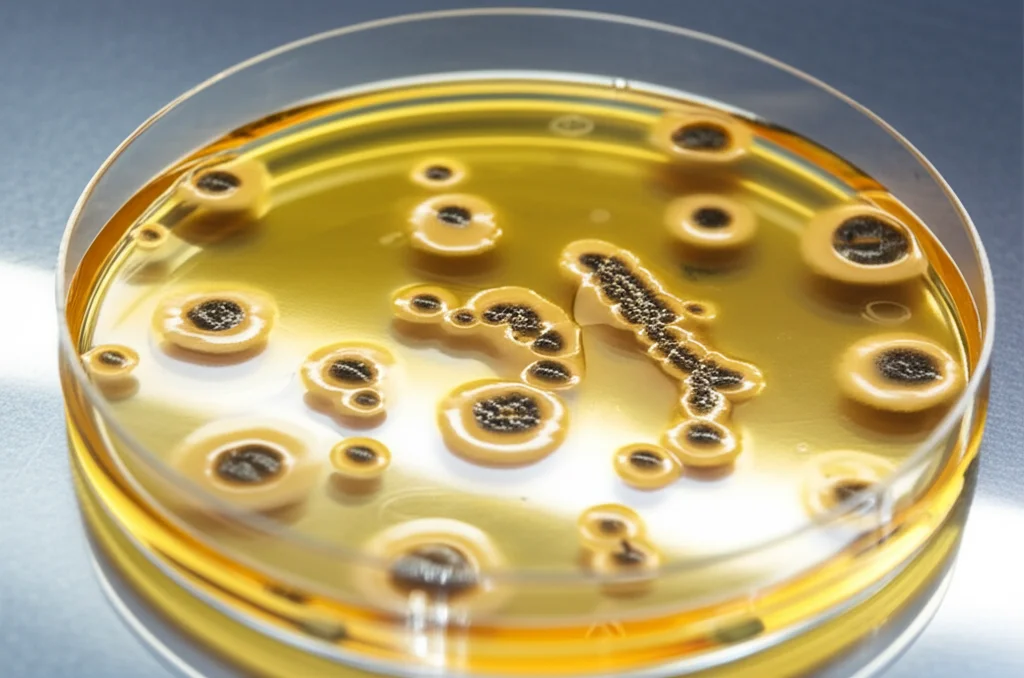
Immagine macro fotorealistica di piastre di Petri con colonie batteriche di Campylobacter in un laboratorio di microbiologia, obiettivo macro 100mm, alta definizione, illuminazione controllata per evidenziare i dettagli delle colonie, sfondo leggermente sfocato.

Campylobacter in Etiopia: Svelato il Complesso e Intrigante Legame tra Uomini e Bestiame!
Ciao a tutti! Oggi voglio portarvi con me in un viaggio affascinante nel cuore dell’Etiopia rurale, per svelare i segreti di un batterio tanto comune quanto misterioso: il Campylobacter jejuni. Magari il nome non vi dice molto, ma pensate che è una delle cause principali di gastroenterite batterica nel mondo. E non solo: nei paesi a basso e medio reddito, le infezioni da Campylobacter, anche quelle senza sintomi evidenti, sono state collegate a un problema serio nei bambini: il ritardo nella crescita (quello che gli esperti chiamano “stunting”). Un bel problema, vero?
Ecco, la cosa strana è che, mentre nei paesi più ricchi sappiamo abbastanza bene come si diffonde (spesso tramite il pollo poco cotto), in contesti come l’Etiopia rurale, specialmente per i neonati e i bambini piccoli, le sue vie di trasmissione sono un vero rompicapo. Ed è proprio qui che entra in gioco la nostra ricerca. Ci siamo chiesti: da dove arriva questo batterio che infetta i bimbi etiopi sotto l’anno di età? Dal bestiame con cui vivono a stretto contatto (polli, mucche, capre, pecore) o magari da altri esseri umani (fratelli, mamme)?
Un’indagine nel cuore dell’Etiopia rurale
Immaginatevi piccoli villaggi nell’area di Haramaya, nell’Etiopia orientale. Qui, la vita quotidiana scorre a stretto contatto con gli animali. Le famiglie allevano bestiame per sussistenza, e non è raro che polli, capre o mucche gironzolino liberamente, anche vicino a dove giocano i bambini. In questo contesto, abbiamo scoperto una prevalenza altissima di Campylobacter nei campioni fecali dei neonati, una prevalenza che aumenta con l’età fino a raggiungere quasi il 90% a un anno! La maggior parte delle volte, per fortuna, non ci sono sintomi evidenti, ma abbiamo notato che una carica batterica più alta è associata a un maggior rischio di diarrea.
Abbiamo anche visto che alcuni fattori sembrano aumentare la carica batterica: l’insicurezza alimentare, certe pratiche alimentari (come dare altri liquidi prima del latte materno, introdurre cibi solidi troppo presto, bere latte crudo), la presenza di mucche e pecore in casa (ma stranamente non polli o capre!), e fattori legati all’igiene (come la gestione non corretta delle feci dei bambini, il contatto con animali o le loro feci, e l’abitudine dei piccoli di mettere terra in bocca). D’altro canto, lavarsi le mani con il sapone e usare biberon con tettarella sembravano protettivi. Insomma, un quadro complesso!
Curiosamente, analizzando più a fondo, abbiamo scoperto che nei bambini circolano principalmente due “specie” di Campylobacter: il nostro amico C. jejuni e un altro, chiamato Candidatus C. infans, che sembra essere ancora più comune (fino al 60% a un anno). Quest’ultimo, tra l’altro, sembra diffondersi principalmente tra esseri umani (quello che chiamiamo trasmissione antroponotica). Il C. coli, un altro parente stretto, era invece quasi assente nei piccoli.

Detective del DNA: Sulle tracce del Campylobacter
Per capire da dove arrivasse il C. jejuni, abbiamo dovuto usare le maniere forti… della scienza! Abbiamo estratto il DNA dai batteri isolati dai campioni (feci di neonati, fratelli, madri, e feci di polli, mucche, capre e pecore) e ne abbiamo sequenziato l’intero genoma (WGS – Whole Genome Sequencing). È un po’ come ottenere l’impronta digitale super dettagliata di ogni singolo batterio.
Analizzando queste “impronte”, abbiamo usato una tecnica chiamata Multi Locus Sequence Typing (MLST), sia nella sua versione classica (basata su 7 geni) sia in una più avanzata (basata sul genoma “core”, cgMLST, che ne analizza ben 1343!). Questo ci ha permesso di classificare i batteri in diversi “tipi” genetici, chiamati Sequence Types (STs).
E qui la prima sorpresa: abbiamo trovato ben 48 ST diversi, di cui 11 completamente nuovi, mai descritti prima! Questo ci dice che c’è una grande diversità genetica di C. jejuni in quest’area. Ma la cosa ancora più interessante è che molti di questi ST erano diversi da quelli che si trovano comunemente nei paesi ad alto reddito. Dei sei ST più diffusi a livello globale, solo uno (l’ST50) era presente nel nostro studio, e per giunta era il più frequente! Questo suggerisce che la storia del Campylobacter in Africa potrebbe essere molto diversa da quella che conosciamo altrove, e che forse abbiamo ancora molto da scoprire perché finora si è studiato poco in queste regioni.
Analizzando gli ST trovati, abbiamo visto che alcuni erano condivisi tra neonati, altri umani e bestiame, mentre altri erano presenti solo nei neonati e nel bestiame. Questo già ci dava qualche indizio sulle possibili vie di trasmissione.
Un ospite di passaggio o un inquilino fisso?
Un altro aspetto affascinante è stato guardare cosa succedeva nel tempo nello stesso bambino. Grazie alla natura longitudinale del nostro studio (abbiamo seguito i bambini per un periodo), abbiamo potuto prelevare campioni in momenti diversi. E cosa abbiamo scoperto? Che isolando più batteri dallo stesso campione prelevato in un dato momento, questi erano quasi sempre dello stesso ST e geneticamente molto simili (differivano per pochissimi “mattoncini” del DNA, meno di 5 alleli nel cgMLST). Questo fa pensare che l’infezione iniziale derivi probabilmente da un singolo evento di trasmissione, seguito da una piccola evoluzione del batterio all’interno dell’ospite.
Ma la vera sorpresa è arrivata confrontando campioni dello stesso bambino presi a distanza di uno o più mesi. Nella stragrande maggioranza dei casi (84%), l’ST trovato nel secondo campione era diverso da quello del primo! Solo in rarissimi casi abbiamo ritrovato lo stesso ST. Questo suggerisce fortemente che non si tratta di infezioni persistenti con lo stesso ceppo batterico che rimane lì per mesi, ma piuttosto di un ciclo continuo di “prendi il batterio – eliminalo – prendine un altro”. I bambini sembrano liberarsi di un tipo di C. jejuni abbastanza rapidamente (nel giro di 1-4 mesi) per poi essere subito reinfettati da un altro tipo presente nell’ambiente. Questo contrasta un po’ con l’idea che le infezioni “persistenti” (definite magari solo dalla positività ai test per più mesi) siano la norma o il problema principale. Qui sembra più una staffetta continua di infezioni diverse!
Il verdetto dei modelli: Chi è il colpevole principale?
A questo punto, avevamo tutte le impronte digitali (i profili genetici) e i sospettati (polli, mucche, capre, pecore, fratelli, madri). Come fare a capire chi infettava chi, e in che misura? Abbiamo usato diversi “modelli matematici di attribuzione”, che sono come degli investigatori virtuali. Questi modelli analizzano le somiglianze genetiche tra i batteri trovati nei neonati (le “vittime”) e quelli trovati nelle potenziali fonti (i “sospettati”) per stimare la probabilità che un’infezione in un neonato provenga da una specifica fonte.
Abbiamo usato ben quattro approcci diversi, basati su tecniche genomiche differenti (cgMLST o k-mers, che sono brevi sequenze di DNA) e su assunzioni statistiche diverse (modelli genetici di popolazione come l’Asymmetric Island model, o modelli di machine learning come le Random Forest basate su PCO-encoding o k-mers). Volevamo essere sicuri che i risultati fossero robusti.
Ebbene, nonostante le differenze tra i modelli, il messaggio principale è stato sorprendentemente coerente: i polli sono risultati essere la fonte primaria delle infezioni da C. jejuni nei neonati! Tutti i modelli hanno puntato il dito contro i polli come i principali “untori”.
C’era qualche differenza tra i modelli riguardo all’importanza relativa degli altri animali: alcuni davano più peso alle mucche, altri ai piccoli ruminanti (pecore e capre messe insieme). Ma il ruolo predominante dei polli era fuori discussione.
Il ruolo degli altri umani: Intermediari o fonti dirette?
Ma non è finita qui. Ci siamo chiesti: e gli altri umani (mamme e fratelli) che ruolo giocano? Potrebbero essere anch’essi infettati dal bestiame e poi, a loro volta, trasmettere l’infezione ai neonati? Per esplorare questa possibilità, abbiamo usato modelli più sofisticati, incluso uno chiamato “source/sink model”, che permette a un gruppo (in questo caso, gli altri umani) di essere sia un “pozzo” (ricevere l’infezione dalle fonti animali) sia una “sorgente” (trasmettere l’infezione ai neonati).
I risultati? Sembra proprio che sia così! I modelli hanno stimato che una quota non trascurabile delle infezioni nei neonati (tra il 16% e il 22% a seconda del modello) potrebbe provenire da altri umani. E da dove prendono l’infezione questi altri umani? Principalmente… dai polli! Quindi, si configura uno scenario complesso: i polli infettano direttamente i neonati, ma infettano anche le mamme e i fratelli, i quali possono poi (magari attraverso le mani non lavate, la preparazione del cibo, ecc.) passare l’infezione ai piccoli. Un vero intreccio! Non possiamo dire con certezza se gli altri umani siano solo dei “vettori” passivi o se il batterio si moltiplichi anche in loro prima di essere trasmesso, ma la loro importanza in questa catena di trasmissione sembra chiara.

Cosa ci insegna tutto questo? Implicazioni pratiche
Ok, abbiamo scoperto che le vie di trasmissione del C. jejuni in questa zona dell’Etiopia sono davvero complesse e interdipendenti. I polli sono i protagonisti principali, ma anche i ruminanti hanno un ruolo, e gli altri esseri umani fungono da ponte importante, probabilmente infettati anch’essi dai polli. Inoltre, non dimentichiamo l’altro attore, Candidatus C. infans, che sembra diffondersi per via umana.
Cosa possiamo fare, allora, per proteggere i bambini da queste infezioni e dal rischio di ritardo nella crescita? I nostri risultati suggeriscono che concentrarsi solo su una fonte (ad esempio, solo sui polli) potrebbe non bastare, data la complessità del quadro.
La strategia più promettente sembra essere quella di intervenire sulle “fonti prossimali”, cioè sui veicoli più vicini al bambino attraverso cui il batterio arriva alla sua bocca. Quali sono? Principalmente:
- Le mani dei caregiver (mamme, fratelli, ecc.)
- Il cibo che viene preparato per il bambino
- Il suolo/pavimento all’interno della casa, dove i bambini magari gattonano e mettono le mani (e poi le mani in bocca)
Proteggere queste vie di esposizione richiede un approccio integrato, che metta insieme interventi che oggi sono spesso separati: nutrizione (promuovere pratiche alimentari sicure), sicurezza alimentare (garantire che il cibo sia preparato e conservato igienicamente) e WASH (acqua, sanità e igiene – promuovere il lavaggio delle mani, la gestione sicura delle feci, la pulizia dell’ambiente domestico).
Insomma, il nostro viaggio nel mondo del Campylobacter etiope ci ha mostrato una realtà intricata, ma ci ha anche dato indicazioni preziose su dove concentrare gli sforzi per migliorare la salute dei bambini in contesti simili. È una sfida complessa, ma capire a fondo queste dinamiche è il primo passo fondamentale!
Fonte: Springer







